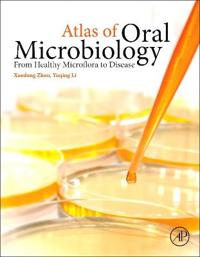

Advances in Intelligent Vehicles (Övrig)
avYaobin Chen, Lingxi Li
ISBN: 9780123971999 - UTGIVEN: 2013-12-02The Series in Intelligent Systems publishes titles that cover state-of-the-art knowledge and the latest advances in research and development in intelligent systems. Its scope includes theoretical studies, design methods, and real-world implementations and applications. Advances in Intelligent Vehicl[...]
Digital Signal Processing (Inbunden)
avLi Tan, Jean Jiang
ISBN: 9780124158931 - UTGIVEN: 2013-03Digital Signal Processing, Second Edition enables electrical engineers and technicians in the fields of biomedical, computer, and electronics engineering to master the essential fundamentals of DSP principles and practice. Many instructive worked examples are used to illustrate the material, and the[...]
Atlas of Oral Microbiology (Inbunden)
avXuedong (EDT) Zhou, Yuqing (EDT) Li, Xuedong (EDT) Zhou
ISBN: 9780128022344 - UTGIVEN: 2015-02Atlas of Oral Microbiology provides a complete description of the oral microbial systems, illustrating them with a large variety of bacteria culture images and electron microscopy photos. This work is by far the most thorough and best illustrated oral microbiology atlas available. In addition, it al[...]
Applied Nonlinear Control (Inbunden)
avJean-Jacques E. Slotine, Weiping Li
ISBN: 9780130408907 - UTGIVEN: 199010Covers in a progressive fashion a number of analysis tools and design techniques directly applicable to nonlinear control problems in high performance systems (in aerospace, robotics and automotive areas).[...]
Fundamentals of Multimedia (Häftad)
avLi Ze-Nian, Mark S. Drew
ISBN: 9780131272569 - UTGIVEN: 200312For one-semester, advanced undergraduate/graduate-level Multimedia courses in departments of Computer Science, Engineering, CIS, and IT. This text fills a gap in the rapidly growing field of multimedia by introducing advanced programming students to the basic concepts of multimedia. Written by exper[...]
Poems (Storpocket)
avLi Po, Tu Fu
ISBN: 9780140442724 - UTGIVEN: 197304Offers translations of poems by the two Chinese writers
Mao's Last Dancer (Storpocket)
avLi Cunxin
ISBN: 9780141040226 - UTGIVEN: 200904Raised in a desperately poor village during the height of China's Cultural Revolution, Li Cunxin's childhood revolved around the commune, his family and Chairman Mao's Little Red Book. Until, that is, Madame Mao's cultural delegates came in search of young peasants to study ballet at the academy in [...]
Mao's Last Dancer (Storpocket)
avLi Cunxin
ISBN: 9780141320861 - UTGIVEN: 200607Tells the true story of a poor Chinese peasant boy who, plucked unsuspectingly at the age of ten from millions of others across the land to be trained as a ballet dancer, turned the situation to his advantage to become one of the world's greatest ballet stars.
Young Reader's Edition.[...]Jeremy Strong's Laugh-Your-Socks-Off Joke Book (Storpocket)
avJeremy Strong, Amanda Li
ISBN: 9780141325132 - UTGIVEN: 2008-08Is it time to pause for breath? No because there's also Streaker the dog, indoor pirates, trolls and superheroes and karate kicking and time-travelling and mad grannies, and so much more. Featuring a brand new short-story by Jeremy, the "Laugh-Your-Socks-Off Joke Book" is jam-packed with jokes, quiz[...]
Li Na: My Life (häftad)
ISBN: 9780143800057 - UTGIVEN: 2014-08In 2008, Li Na left China's national sports system under an experimental programme for tennis players that enabled them to 'fly solo', which, in three short years, led to her career-defining win at the French Open. "Li Na: My Life "is the remarkable story of her journey from young tennis talent to t[...]
Modern Organic Synthesis in the Laboratory: A Collection of Standard Experimental Procedures (Inbunden)
avJie Jack Li, Chris Limberakis, Derek A. Pflum
ISBN: 9780195187984 - UTGIVEN: 2008-01-10Modern Organic Synthesis in the Laboratory (Häftad)
avJie Jack Li, Chris Limberakis, Derek A. Pflum
ISBN: 9780195187991 - UTGIVEN: 2008-01Searching for reaction in organic synthesis has been made much easier in the current age of computer databases. However, the dilemma now is which procedure one selects among the ocean of choices. Especially for novices in the laboratory, it becomes a daunting task to decide what reaction conditions[...]
Conversations with Ogotemm Li: An Introduction to Dogon Religious Ideas (Häftad)
avMarcel Grianle, Marcel Griaule, Germaine Dieterlen
ISBN: 9780195198218 - UTGIVEN: 1975-11Laughing Gas, Viagra, and Lipitor (Inbunden)
avJie Jack Li
ISBN: 9780195300994 - UTGIVEN: 2006-09The stories behind drug discovery are fascinating, full of human and scientific interest. This is a book on the history of drug discovery that highlights the intellectual splendor of discoverers as well as the human frailty associated with them. History is replete with examples of breakthrough medic[...]
Triumph of the Heart: The Story of Statins (Inbunden)
avJie Jack Li
ISBN: 9780195323573 - UTGIVEN: 2009-04-23Li Ka-Shing (Häftad)
avAnthony B. Chan
ISBN: 9780195900767 - UTGIVEN: 1997-03This is the biography of billionaire Li Ka-shing, the ultimate Hong Kong rags-to-riches success story. The book follows his life from his poor family's flight from the Japanese to Hong Kong in 1940, to his famous takeover of the British hong Hutchison Whampoa in 1979, and expansion of his business e[...]
Problems In Structural Inorganic Chemistry (Pocket)
avWai-kee Li, Yu-san Cheung, Kendrew Kin Wah Mak, Thomas Chung Wai Mak
ISBN: 9780199658503 - UTGIVEN: 2012-10-25This volume serves as a problem text to accompany the book Advanced Structural Inorganic Chemistry (Oxford University Press, 2008). It may also be used as a supplement for a variety of inorganic chemistry courses at the senior undergraduate level.[...]
Blockbuster Drugs (Inbunden)
avJie Jack Li
ISBN: 9780199737680 - UTGIVEN: 2014-01Blockbuster drugs-each of which generates more than a billion dollars a year in revenue-have revolutionized the industry since the early 1980s, when sales of Tagamet alone transformed a minor Philadelphia-based firm into the world's ninth-largest pharmaceutical company. In Blockbuster Drugs, Jie Jac[...]
Inside Java 2 Platform Security (Pocket)
avLi Gong, Gary Ellison, Mary Dageforde
ISBN: 9780201787917 - UTGIVEN: 2003-05-27Tower for the Summer Heat, A (Övrig)
avYu Li
ISBN: 9780231113854 - UTGIVEN: 1998-08-20Li Yu, considered a master of comedy in Chinese literature, was a novelist, playwright, and essayist in the 17th century. In this collection, patrick Hanan has translated six of the twelve stories in the Sh'ier lou collection, which is one of the most famous individual collections of vernacular stor[...]
Primer for Advanced Beginners of Chinese, Traditional Characters, A: v.1 (Pocket)
avZhirong Wang, Yanping Xie, Duanduan Li, Irene Liu, Lening Liu, Wang Hailong
ISBN: 9780231125550 - UTGIVEN: 2003-07-16